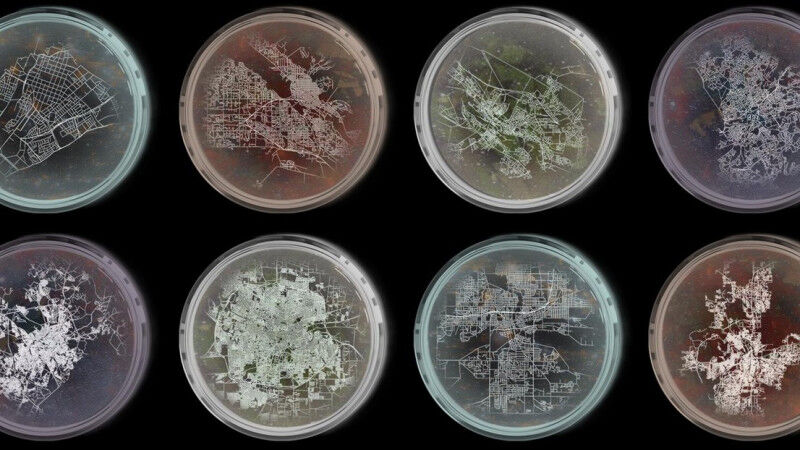

An EPFL study has found that urban areas follow the same universal rules observed in the natural world. From population size to carbon emissions and road networks - could the key to sustainable urbanization lie in the very "metabolism" of our cities?
Since the rise of Western megacities, novelists have often likened the city - and its productive systems - to a living organism. Indeed, urban areas have been referred to in various anatomical terms: a "belly" by Émile Zola, a "hand" by Italo Calvino, "lymph" by Michel Butor and a labyrinthine state of mind by Paul Auster.
Researchers have been exploring this same analogy for more than a decade , with a practical aim in mind: to simplify the inherent complexity of urban systems and inform planning. Because understanding how cities actually work, could provide a blueprint for a sustainable urban future. These research efforts have focused on one hypothesis in particular: "bigger" cities are "better" as they require less resources but generate more wealth - as explained by urban scaling laws, in analogy with Kleiber’s law for living organisms. Max Kleiber, a Zurich biologist, discovered in the 1930s that larger animals use energy more efficiently because biological systems are characterized by branching transport networks that optimize energy dissipation and resources allocation.
scientists have just published research that generalizes these scaling laws from neighborhoods to global cities. This lends new weight to the intuitive analogy drawn by novelists. Their findings, which are based on millions of data points from more than 100 cities worldwide, appear in the prestigious Proceedings of the National Academy of Sciences (PNAS).
Identical scaling curves
The scientists examined three variables: urban population (analogous to an animal’s mass), carbon emissions (equivalent to the metabolic rate of a living organism) and road networks (the circulatory system). "When properly rescaled, we found that the probability distributions of these variables follow a unique curve for all cities - large and small - implying that urban form and functions are governed by universal laws similar to those that apply to living organisms," says Gabriele Manoli, the study’s corresponding author and head of EPFL’s Laboratory of Urban and Environmental Systems (URBES).
The findings also suggest that a form of self-organization naturally emerges as cities grow - although, as Manoli explains, there is one important caveat: "Contrary to what’s often been claimed, large cities aren’t necessarily more sustainable than small ones - what matters is the covariation in space of population density, transport networks, and economic activities, which are all’inter-related."
A new method
In Kleiber’s law, animals have a well-defined average size. With cities, sizing is trickier: their boundaries can vary widely depending on how they are defined - and scaling laws can lead to confounding results (for example, bigger cities can be considered greener or less green in terms of emissions). To overcome this hurdle, the authors divided each city into smaller units - like "pixels" - and employed a finite-size scaling approach.
This approach was originally proposed by colleagues at EPFL, including Andrea Rinaldo, honorary professor and co-author of the study, to explain "intra-species variations" in Kleiber’s law. As for biology, where the mass and metabolic rate of a species can vary among individuals (and these variations can largely differ from the average value considered by Kleiber), so urban characteristics vary from neighborhood to neighborhood, and a city is better characterized by a distribution of values rather than a single number.
We have mathematically demonstrated that the spatial organization of cities exhibits general emergent properties despite geographical, political, and historical differences.
Gabriele Manoli
A systemic approach
For Manoli, these findings mark an important step forward for urban research: "We have mathematically demonstrated that the spatial organization of cities exhibits general emergent properties despite geographical, political, and historical differences - therefore, planners need to take a systemic approach and consider the complex and dynamic nature of urban evolution." He also argues that cities resemble living organisms rather than controllable machines. For him, any effort to design more sustainable territories should therefore go beyond single sectors and operations: planning should consider entire urban areas, their multi-scale behavior, and their continuous exchanges with the surrounding, almost global, environment. "Thanks to the vast amount of data available, cities offer a fertile ground to test new theories inspired by biology and ecology" Manoli said.
Manoli’s team hopes that, by considering more variables and their temporal evolution, they will obtain further insights into the laws that govern the most human of creations: the modern city.
ReferencesMartin Hendrick, Andrea Rinaldo and Gabriele Manoli, "A stochastic theory of urban metabolism," Proceedings of the National Academy of Sciences (PNAS), 11 August 2025. https://doi.org/10.1073/pnas.2501224122



